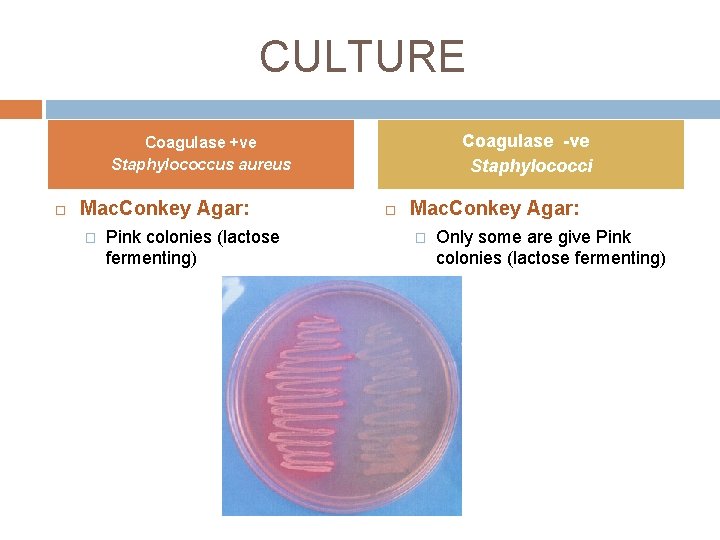
CULTURE Coagulase -ve Staphylococci Coagulase +ve Staphylococcus aureus Mac. Conkey Agar: � Pink colonies CULTURE Coagulase -ve Staphylococci Coagulase +ve Staphylococcus aureus Mac. Conkey Agar: � Pink colonies

STAPHYLOCICCI Lecture 3 Staphylococcus sp Morphology Gram positive

















- Slides: 17

STAPHYLOCICCI Lecture # 3

Staphylococcus sp. Morphology: � Gram positive cocci. � In clusters Culture: � Facultative anaerobes � Incubation 37ºC x 24 hr

Staphylococcus sp. Coagulase +ve: � Staphylococcus aureus. Coagulase –ve: � Staphylococcus saprophyticus. � Staphylococcus epidermidis. All Staphylococci are CATALASE +VE

CULTURE Coagulase +ve Coagulase -ve Staphylococcus aureus Staphylococci Blood Agar: � Creamy colonies 1 -2 mm � Grayish white colonies � Beta-heamolysis � No heamolysis
CULTURE Coagulase -ve Staphylococci Coagulase +ve Staphylococcus aureus Mac. Conkey Agar: � Pink colonies (lactose fermenting) Mac. Conkey Agar: � Only some are give Pink colonies (lactose fermenting)

CULTURE Coagulase +ve Coagulase -ve Staphylococci Staphylococcus aureus Mannitol Salt Agar: � Growth � Change color from Red to Yellow (Mannitol fermenting) � No yellow color no fermentation. Differential: Staph aureus can frement mannitol and give diffused yellow color Selective: Containing very high salt conc only staph can grow

Biochemical Tests are: 1 - Catalase 2 Coagulase 3 -DNase 1. Catalse: 2 H 2 O 2 + 2 H 2 O Streptococci vs. Staphylococci

Coagulase Test 2. Coagulase test: � Fibrinogen in plasma Fibrin Free (tube) coagulase: A. 1. 2. 3. 4. 1 ml pepton + 1 ml EDTA plasma Emulsify loop full of organism Incubate 30 min x 37ºC If negative incubate at RTº overnight

Coagulase Test Coagulase Positive Coagulase Negative

Coagulase Test B. Bound (slide) coagulase: One drop of saline on clean slide 2. Emulsify loopful of organism in saline 3. Add one drop of plasma 4. Mix rocking for 2 min 1.

Coagulase Test (Latex agglutination test) • • • Several latex agglutination test kits are available to identify Staphylococcus aureus. Latex particles coated with fibrinogen. Rapid clumping of latex particles occurs when mixed with colony material of S. aureus.

Biochemical Tests 3. DNase Test: 1. 2. 3. 4. 5. 6. DNase enzyme hydrolyze DNA Spot-inoculate organism on a DNA containing media Incubate 37ºC x 24 hr Flood plate with 1 mol/ml HCL sol HCL will precipitate unhydrolyzed DNA Tip off the excess acid Clearing around colonies DNase positive strain No Clearing around colonies DNase negative strain

MRSA (methicillin resistant Staphylococcus aureus) • These strains are resistant to methicillin and related penicillins and are particularly difficult to treat because they are also resistant to most other common antibiotics. • MRSA strains cause hospital infections, particularly wound infection and septicaemia. • Vancomycin is often needed to treat MRSA infections.

Coagulase Negative Staphylococci Novobiocin Disk: � Staphylococcus saprophyticus Resistant � Staphylococcus epidermidis Sensitive

Micrococcus Gram Positive Cocci in pairs and tetrads. Catalase +ve. Generally harmless, but can cause disease in immunocompromised host.

Micrococcus Blood agar or chocolate agar: Small, non-hemolytic, variably pigmented (white, orange, yellow pink) colonies. Mac. Conkey: no growth.

Your Work For Today. 1. Prepare Gram Stain, show it to the instructor. 2. Perform Catalase test. 3. Perform Coagulase test. 4. Perform DNA’s test. 5. Do subculture of the organism to: Ø Blood agar plate. Ø Mannitol Salt Agar.